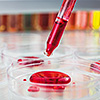

Biológia gimnáziumoknak 10.
Textbook
Mozaik
MS-2649 - Edition 3,
2024
224 pages
Authors: Gál Béla

Gál Béla népszerű gimnáziumi biológia tankönyvsorozatának legújabb kötete a NAT2020 alapján készült, követve a korábbi MS-2641, MS-2642 és MS-2643 Biológia 10., 11. és 12. évfolyamos kötetekben megszokott alaposságot és szakmai megbízhatóságot.
Elsősorban azoknak ajánljuk, akik biológiából szeretnének érettségizni.
-
Az élő rendszer anyagai
-

A sejt és a genom
-

Az egyedszintű öröklődés
- A genetika 80
- Egy gén által meghatározott tulajdonságok öröklődése 83
- Többgénes öröklődés 89
- A kapcsoltság 92
- A nemhez kapcsolt tulajdonságok öröklődése 95
- A mennyiségi jellegek és az extranukleáris öröklődési tulajdonságok 99
- Az emberi jellegek és betegségek öröklődése 101
- A gének és a környezet viszonya 106
- Összefoglaló tesztfeladatok 109
-

A biológiai evolúció
-

A Föld és a Kárpát-medence életközösségei
- Ökológia 142
- A populáció 144
- Az élettelen ökológiai tényezők I. 148
- Az élettelen ökológiai tényezők II. 153
- Az élettelen ökológiai tényezők III. 157
- Az élő ökológiai tényezők 160
- Az életközösségek 164
- Az anyag és az energia mozgása az ökoszisztémában 169
- Az ökológiai stabilitást veszélyeztető tényezők 173
- A biomok mint életközösségek 176
- A Kárpát-medence élővilága 182
- Intrazonális társulások 185
- A víz által befolyásolt intrazonális társulások 187
- A Kárpát-medence állatvilága 190
- Összefoglaló tesztfeladatok 192
-

Ember és bioszféra


